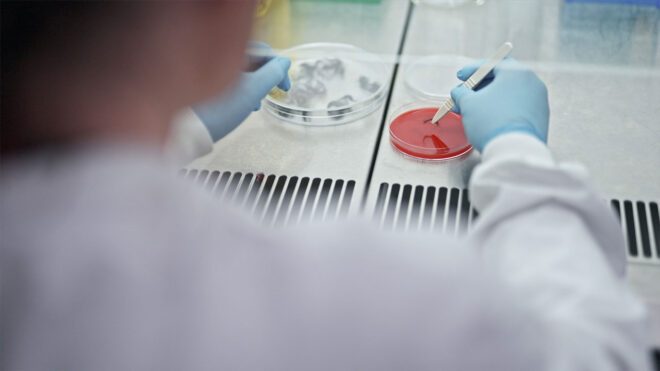

Patili dostlarınız Dyson’a emanet!
Dyson, evlerde en iyi temizliği sağlamak için tasarlanan Anti-tangle tarak teknolojisinin ve Evcil Hayvan Bakım Seti’nin yanı sıra, yeni bir yüzey çizmeyen toz alma fırçası ve kıvrılabilen aralık temizleme başlığını satışa sunuyor.
Gelişmiş Anti-tangle tarak teknolojisi: Dyson’ın en son kablosuz süpürge serisinde olan yeni Anti-tangle tarak teknolojisi, kedi ve köpek dostlarımızdan düşen tüylerle veya insanlardan dökülen uzun saçlarla başa çıkmak için tasarlandı. Dolanmayı önleyen bir taraktan ilham alan fırça çubuğu, tüm tüy tiplerini doğrudan temizleme başlığına aktarmaya yardımcı olmak için hassas açılı tüy alma kanallarına sahip. Bu polikarbonat dişler; bir dizi spiral naylon kıl, anti-statik karbon fiber iplikler ve güçlü emiş gücüyle birleştiğinde, temizlenmesi zahmetli saç ve tüylerin yanı sıra daha büyük döküntüleri ve mikroskobik tozu yakalayıp ortadan kaldırıyor.
Evcil Hayvan Bakımının Önemi Atlanmamalı
Tüyler çoğu evcil hayvanın olmazsa olmazı ve onları aslında dış etmenlere karşı koruyan bir kalkan. Fakat evcil hayvan sahipleri içinse evdeki tüylerin temizliği en can sıkıcı konulardan. Bu konu nedeniyle birçok evcil hayvan sahibinin dostlarını terketmesi veya sahiplendirmesi de üzücü bir sonuç olarak ortaya çıkıyor.
Veteriner Hekim, Köpek Eğitim ve Davranış Uzmanı Tarkan Özvardar evcil hayvan bakımına ilişkin önemli noktaları paylaşarak “Özellikle köpekler doğalarının getirdiği bir özellik olarak bazı ırklar dışında sene boyunca tüy dökmeye devam eder. Köpeklerin derisi tüylerle kaplı olduğundan bakıma ihtiyaç duyar ve bu bakımın gerçekleştirilebilmesi için köpeklerin bizlerin yardımına gereksinimi vardır.
Düzenli tüy bakımı, özellikle tarama ve tımarlama büyük önem arz eder. Çoğu köpek sahibi bu tüylerden kurtulmak için ya köpeklerini sık yıkar ya da sene içinde 2 veya 3 defa makine tıraşı yaptırır. Ama sık yıkanmak köpeklerin derisini kuruturken, makine tıraşı köpeklerin psikolojisini olumsuz etkiler, tüy defansı azaldığından onları yaralanma gibi dış etmenlere, dış parazitlere ve özellikle yaz aylarında güneşin zararlı ışınlarına karşı korunmasız hale getirir.
Bunun yanı sıra makine tıraşı kontak dermatit ve köpekten köpeğe bulaşabilen mantar, uyuz gibi deri hastalıklarına aracılık eder. Makine tıraşında kullanılan aparatın ucundaki metal de ısındığından köpeklerin derisi bu süreçte dağlanmaya başlar ve birtakım folikülit riskler doğar.
Tüylerden kaçınabilmek için seçilen bu yollar sevimli dostlarımız için sağlık açısından olumsuz sonuçlar doğurur. Burada yapmamız gereken düzenli taramadır. Düzenli tarama yapıldığında köpeğin derisi ve tüyleri kokmaz, böylelikle sık yıkamaya ihtiyaç duyulmaz. Köpekler üzerinde kullanılacak doğru tarama aparatlarıyla tüy dökülmesi en aza indirileceğinden makine tıraşına da gerek kalmaz.” diyor.
İLGİNİZİ ÇEKEBİLİR
Köpeklerden eşeklere kadar tüy çeşitliliği
Dyson mühendisleri ve mikrobiyologları, problemi gerçekten anlamak için incelemelerine kedi ve köpek gibi çeşitli hayvanların yanı sıra alpaka, eşek, at ve tavşan gibi daha sıra dışı hayvanları da dahil etti. Bu araştırma, ekibe hayvan türleri ve ırkları arasındaki tüylerin boyutu, dokusu ve yapısının yanı sıra, eve getirebilecekleri görünmez alerjenler ve bakteriler hakkında da ayrıntılı bilgi verdi. Geliştirme ekibi, geleneksel mühendislik yöntemlerine ek olarak, 284 farklı tüy lifi simülasyonu oluşturmak için yüksek hızlı kamera görüntülerini Hesaplamalı Akışkanlar Dinamiği (CFD) yazılımıyla birleştirdi.
Bu, farklı uzunluktaki tüylerin yüksek hızlı hava akışı ve teknolojilerin sanal prototipleriyle nasıl etkileşime girdiğini tekrarlayarak, ihtiyaç duyulan fiziksel prototip sayısını azaltırken araştırmalarını en üst düzeye çıkarmalarına olanak tanıdı. Bu araştırma, Dyson mühendislerinin tüm tüy tiplerinde dolanma önleyici performansını korurken, tüy alma kanallarını fırça çubuğunun boyutlarına uyacak düzeyde hassas bir şekilde tasarlamalarını sağladı.
Dyson Mikrobiyoloji Araştırma Görevlisi Monika Stuczen konuya ilişkin açıklamasında, “Evcil hayvanların evdeki etkisi, görebildiğimizin çok ötesinde. Evcil hayvan tüylerini etkili bir şekilde temizlemek önemli, ancak kurumuş tükürükle evcil hayvan tüyü çıplak gözle görülemeyen bir problemdir. Bu mikroskobik partiküller, evde alerjiye neden olan proteinleri taşıyabilir.
Hafif ve ufak olduklarından saatlerce havada kalabilir veya nesneler arasında gezinebilirler. Araştırmalarda, kedilerin hiç bulunmadığı odalarda dahi kedi alerjenlerine rastlandı. Bu nedenle Dyson teknolojilerindeki uygun filtreleme, tüm evde daha temiz bir ortam sağlamak için hayati önem taşıyor.” diyor.
Küresel Toz Araştırmasından Çıkan Önemli Sonuçlar
Dyson’ın geçtiğimiz sene yaptığı Küresel Toz Araştırması’na göre evcil hayvan sahipliği tüm dünyada giderek artarken, dünya üzerindeki 5 evden 2’sinde evcil hayvan bulunuyor. Türkiye’de yüzde 58 oranla kedi sahipliği dikkat çekerken bunu yüzde 38’le kuş ve yüzde 30’la köpek takip ediyor. Çoğu kedi sahibi evcil hayvanının evinde dolaştığı noktaları fazla sınırlandırmazken, köpek sahipleri bu konuda biraz daha sınırlayıcı.
Araştırmaya göre köpeklerin daha çok ortak alanlarda dolaşmasına izin verilirken, araştırmaya katılanların yalnızca yüzde 32’si köpeklerinin yataklarına çıkmasına izin veriyor, kedilerdeyse bu oran yüzde 37. Yine Türkiye’de yaşayanlar evcil hayvanlarının yatak odası zeminlerinde uyumasına izin vermede katı bir duruş gösteriyor.
Gösterişli kürkler
Dyson, tüm kablosuz süpürgeleriyle uyumlu Evcil hayvan bakım setini kullanıcılarla buluşturuyor. Evcil hayvan tüyleri, evinizin her yerine polen ve diğer alerjenleri taşıyabiliyor. Buna karşılık, evcil hayvan sahiplerinin birçoğu tüylü dostlarının gizli etkilerinden habersiz. Dünyanın dört bir yanından temizlik alışkanlıklarını araştıran Dyson’ın Küresel Toz Araştırması’na göre, Türkiye’deki evcil hayvan sahiplerinin sadece yüzde 29’u ev tozu akarlarının, yüzde 20’siyse ev tozu akarı dışkısının varlığını biliyor.
Köpeğinizin dökülen tüylerini, kepeklerini ve mikroskobik deri pullarını anında yok etmek için tasarlanan Evcil hayvan bakım seti, artık Dyson’ın kablosuz süpürge teknolojileriyle uyumlu olarak çalışıyor. Makinenin ana gövdesine veya bir uzatma hortumu aracılığıyla takılan, 35° açılı, 364 kıla sahip olan başlık, siz evcil hayvanınızı fırçalarken esneyerek köpeğinizin tüylerini almak için hızlı ve rahat bir şekilde köpeğinizin kürküne ulaşıyor.
Veteriner Hekim, Köpek Eğitim ve Davranış Uzmanı Tarkan Özvardar, Evcil hayvan bakımı setinin önemini “Dyson Groom Tool, köpeklerin dökülmeye yüz tutan zayıflamış ve ölü tüylerinin vücutlarından uzaklaştırılmasının yanı sıra deri üzerindeki akar ve döküntülerin de temizlenmesine yardımcı olarak hem köpeklerin hem de sahiplerinin sağlıklarını koruma anlamında önemli bir işlevselliğe sahip.” diyerek özetliyor.
Her temizlik ihtiyacı için bir aksesuar
Dyson’ın son Küresel Toz Araştırması, insanların yüzde 95’inin bir önceki yıla göre daha fazla temizlik yaptığını ortaya koydu. Yalnızca Zemin ve halı temizlemenin ötesinde tasarlanan kablosuz süpürgeler, doğru başlıklarıyla yatağınızdan kitap raflarınıza kadar her şeyi temizlemek için kullanılabiliyor ve tüm evinizde daha hijyenik bir ortam oluşturmaya yardımcı oluyor. Tüm kablosuz süpürge başlıkları aynı amaca yönelik geliştirilmezken, Dyson’ın farklı aksesuarları, tıpkı Dyson kablosuz süpürgeler gibi bir problem çözmek için hassas bir şekilde tasarlandı.
Yüzey Çizmeyen Toz Alma Fırçası – Dyson’ın ilk kendi kendini temizleyen ultra yumuşak toz alma fırçası
Geleneksel toz alma aparatlarında kiri çıkarabilmek için yüzeyleri yanlışlıkla çizebilen kalın kıllar kullanılabilirken, Dyson’ın yeni Yüzey Çizmeyen Toz Alma Fırçası, ince boya ve makyaj fırçalarından ilham alarak, 8.100 ultra ince ve yoğun şekilde sıkıştırılmış Polibütilen Tereftalat (PBT) polimer ipliklerle donatıldı. Hassas yüzeylerin çizilmesini önlemek için kıllar sadece 0,05 mm’ye kadar inceltildi. Ayrıca döner bir manşete sahip olan fırça, kıllardaki toz ve kalıntıları hijyenik ve kolay bir şekilde temizliyor.
Zor noktalara ulaşmak – Dyson’ın Kıvrılabilen Aralık Temizleme Başlığı
Diğer sert aralık aparatlarını dar alanlarda kullanmak zor olabilirken, esnek aralıklı aletler büküldüklerinde emiş gücünü kaybedebiliyor ve biriken kalıntılardan dolayı kolayca tıkanabiliyor. Dyson’ın yeni Kıvrılabilen aralık temizleme başlığı 22 derece dönüyor. Değişen açılarda test edilen çoklu prototipler 22 derecelik açıyı, evinizin veya arabanızın etrafındaki ulaşılması en zor yerleri temizlemek için en uygun açı olduğunu ortaya çıkardı.
Yalnızca 12,5 mm ve 254 mm erişim genişliğiyle dar boşluklara ulaşmak ve derinlere kadar temizlemek için tasarlanan başlık, ayrıca, daha inatçı kirlerin üstesinden gelmek için uç kısmında ikincil bir fırça sunuyor. Dyson’ın 12 kablosuz süpürge aksesuarından oluşan eksiksiz paketinin yeni üyeleri olan bu iki başlık, kullanıcıların her temizlik ihtiyacı için doğru başlıkları kullanmalarını sağlıyor.
Dyson V8 kablosuz süpürge, Anti-tangle teknolojisiyle yenilendi
İlk olarak 2016 yılında piyasaya sürülen Dyson V8 kablosuz süpürge, 40 dakikaya kadar sorunsuz temizlik sağlamak üzere tasarlandı. Şimdi evcil hayvanların geride bıraktığı görünür kirleri yakalamak için Dyson V8™ kablosuz süpürge’nin yeni Motorbar temizleme başlığı Dyson’ın tüy yakalama teknolojisiyle geliştirildi. Evcil hayvan tüyü ve alerjen boyutundaki görünmez partikülleri de yakalamak için filtrelemesi de en yeni Dyson V15 modelleriyle uyumlu olarak 0,3 mikronda yüzde 99,97’den yüzde 99,99’a yükseltildi.

![Epic Games Store, yeni oyun hediyelerini duyurdu [19 Mart]](https://www.log.com.tr/wp-content/uploads/2026/03/2026-03-17_16-14-15_TZ410-300x169.jpg)


